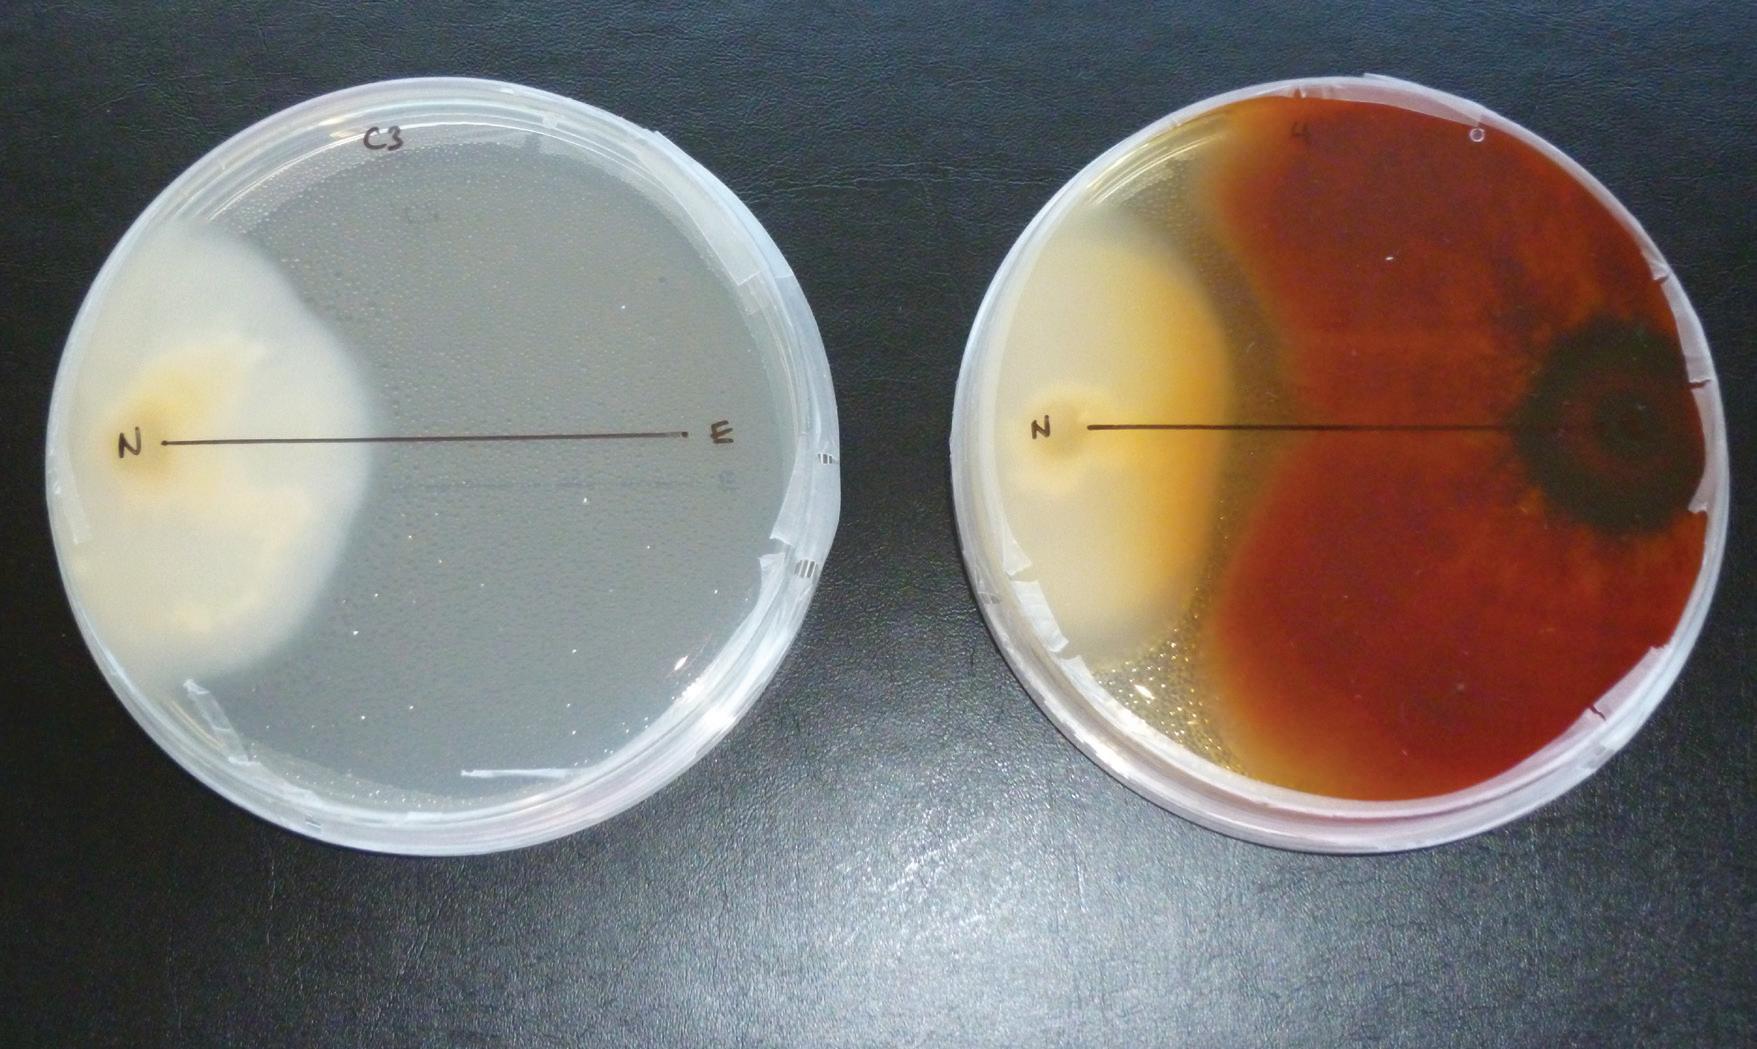

Handbook 2024

6 November 2024
National Fruit Show






































































































![]()

6 November 2024























































































































I am delighted to be the Show’s new Chairman and thank you for your support.

Nigel Bardsley, Chair of the National Fruit Show
I would like firstly to thank Sarah Calcutt for all her hard work over many years as Chairman of the Show.
I have been associated with the Show for most of my life, from watching my parents meticulously preparing their winning Bramley entries in the 60’s to being a judge’s steward and latterly ensuring the Bardsley entries had the best storage regime possible.
To me the show represents the best of British apple and pears, and it is a great showcase for our Industry.
This year we have a new team with Claire Seymour taking over as Chairman of Trustees and Eileen Haffenden returning as the Show Manager. We are extremely lucky to have her on board, a powerhouse of organization and tact. Annette continues as my Vice Chairman and Chair of Competitions and Chris Morris is our Treasurer.
In its 91st year we have changed to a new look one day show. The show will be opened at 9.30am by Tom Bradshaw, the new President of the NFU, preceded by the President’s Breakfast.
At 5pm everyone is invited to bubbles and nibbles at the Trophy Stand for the traditional prize giving. The Bonanza Prize will be drawn by Chris Hutchinson from New Spitalfields Market and the raffle will be drawn in aid of the Education Programme.
There will be no show dinner, soft fruit, juice or cider competition classes but at its heart will be, as always, a breath-taking display of top fruit.
I believe that over the years showing fruit has had a very positive effect on the Bardsley’s business particularly for staff moral and esteem. I would encourage every grower to give it a go. An entry form and information are included in this Handbook, and there is help if needed within the Show.
I’m pleased to say that the Education Programme is going from strength to strength under the guidance and enthusiasm of Mandy Hounsell and her helper Irainne Styles. Every year more schools and Shows are asking them to attend their as their presentation is recognised as part of the early learning and key stages 1, 2 3 and 4 of their curriculums. However, we do need more funding to come forward to realise the program’s potential. So, for the first time you will be able to buy the fruit being exhibited, with proceeds going to the Education programme, as well as the usual raffle.
This Show would not take place without our major sponsors, N P Seymour, Hutchinsons and OnePay and all the other companies who sponsor the show classes, banners, hospitality and events throughout the year.
Finally, thank you to all the volunteers who help stage the Show from the Sunday night to close of play on the Wednesday.
For the exhibitors the Show is your opening to showcase your new products and innovations and liaise with your customers old and new.
I am looking forward to catching up with you all at the show. ■
09.00 Show opens
09.00 President’s breakfast (invite only)
09.30 NFU President Tom Bradshaw officially opens and tours the show
Reverend Nicky Harvey at St Michael & All Angels Marden will give a blessing of the fruit
17.00 Trophy presentation
18.00 Show closes

Who’d have believed it possible? The past year uncovered yet more challenges at every level that will take focus and flexibility to circumnavigate. There have also been promising signs of change.
This year’s National Fruit Show – the premier event for the top fruit industry – will bear witness to this and to the resilience and fortitude of growers, their suppliers and their advisers. It’s great to be back.
“Sometimes you need to eat an entire cucumber. Let me show you the best way to do it.” So started a TikTok revolution. A young man, Logan Moffitt, has taken the internet by storm with offbeat and exciting recipes for cucumber, with the first attracting 13 million views. Subsequent postings have racked up over 30 million. Moffitt has secured nearly six million followers for himself and many other influencers have begun looking for ways to take the cucumber to new heights. The effects are now being felt in the supply chain, initially causing many retailers to experience shortages.
What’s all this got to do with fruit? Directly, not much, but for the humble cucumber to pivot so dramatically is surely remarkable. Think what could happen with the betterloved British apple in its fight to gain advantage over competitors. It’s all about winning hearts and markets.
One Kent grower admitted in August that this had been the most difficult year they had known in 35 years of top fruit growing. Combatting disease has been relentless. Despite challenges for businesses at every level, including for today’s event, continuing support for the National Fruit Show has been palpable, and for that we are thank all

Catherine Paice, President of the National Fruit Show
our supporters, both loyal and new. The aim of promoting access to knowledge and best practice relating to the growing, storing, packaging and marketing of fruit remains at the heart of the Show.
In my second year as President, I continue to be impressed by the dedication, appetite and determination of this industry, by the technical and scientific advances, and by the efforts to educate young people and encourage them into the industry. It is so important that the role of British fruit on British shelves and plates is kept in the public eye, and while this is largely a trade
show, part of our role is spreading message beyond the excellent Kent Showground.
The educational role played by the Marden Fruit Show Society and the Show in sharing knowledge and bridging gaps cannot be underestimated. Our own Apple World, now being delivered by the energetic skills of Mandy Hounsell, has had an extraordinarily successful year, making learning fun as well as informative, and slotting into the secondary as well as primary school curriculum.
With experience in a number of sectors, I am all too well aware of the struggle to maintain British food production, especially in these inflationary times. There is also extreme geopolitical volatility. Food security, as well as availability and price, needs to be further up the political agenda. This Show can help focus on innovation, addressing the skills
shortages, profitable production, quality, feeding the needy and encouraging the next generation of growers and workers.
On that note, I’d like to pay tribute to the work of NFS Committee Chairman Nigel Bardsley, Trustees Chair Claire Seymour (N P Seymour are celebrating 50 years in business), MFSS Manager Eileen Haffenden and all committee members who have taken the time and trouble to exhibit, compete, and support this year’s Show. Also to extend thanks from us all to our valued key sponsors – Hutchinsons, N P Seymour and OnePay – and all standholders and competition sponsors.
Enjoy the Show. It is a great showcase, and one of the biggest of its kind in the world. We can help create the buzz that the industry needs. The ultimate goal is for British fruit to become the consumer’s first choice. ■



The success of the Show is down to the invaluable support of all our sponsors.
Major sponsors

Show supporters

Bonanza Prize
Presidents breakfast and Show opening
Trophy presentation reception
Judges’ lunch
Media sponsor Competition packaging
®

Transport














































































































































President
Catherine Paice
Chair
Nigel Bardsley
Vice Chairman
Annette Bardsley
Treasurer
Chris Morris
Manager
Eileen Haffenden
Education
Mandy Hounsell
Irainne Styles
Chair of Competitions
Annette Bardsley
Competition Secretary
Mary-Anne Langran
Senior Steward
James Goldsworthy
Chairman of the Judges
Jonathan Blackman
Judges
Christopher Atkinson
Colin Bird
Dr Jonathan Blackman
Richard Brewer
Andy Bull
Charnee Butcher
Sarah Calcutt
Fokion Chatziavgerinos
Richard Gaskin
Nigel Jenner
Philip Opie
Gary Saunders
Julian Searle
James Shillitoe
Ivan Velasco
Ryan Williams
Joanna Wood
Chair of Trustees
Claire Seymour
Vice Chair of Trustees
Robert Mitchell
Trustees
Annette Bardsley
Jonathan Blackman
Colin Bird
Kathleen Kelliher
Chris Morris
General Committee
Members
Annette Bardsley
Jonathan Blackman
John Breach
Ben Brown
Richard Gaskin
James Goldsworthy
Adrian Harris
Jon Hatch
Suzie Kember
Jamie McGrorty
Chris Morris
Tom Ogden
Robert Oliver
Brendan Rhodes
Nick Seymour
Claire Seymour
Chris Tanton
Joanna Wood

Best exhibit in Show
69 The NFU Prize of £400
70 The Roderic Sarson Memorial Trophy – Best all round exhibit of apples
Best exhibit of culinary apples
72 The Podger Norton Trophy – Best exhibit of culinary apples
75 The Fruiterers Company Medal – The most meritorious exhibit of culinary apples
77 The Fyffes Salver – Best exhibit of Bramley
86 The Dan Wuille Cup – Exhibit of culinary apples showing the best colour and skin for variety
Best exhibit of dessert apples
71 The Stokes Bomford Rose Bowl – Best exhibit of dessert apples
74 The Fruiterers Company Medal – The most meritorious exhibit of dessert apples
78 The UKF Fertilisers Cup – Best exhibit of Cox’s Orange Pippin or any Sport
79 The John Henshall Salver – Best exhibit of any dessert apple grown in the UK outside Kent
87 The R Mitchell Challenge Cup – Best exhibit of any dessert apple variety introduced to the UK after 2000
Best exhibit of pears
73 The Bayer Rose Bowl – Best exhibit of pears
76 The Fruiterers Company Medal – The most meritorious exhibit of pears
Exhibitors Under 40
42 Arthur Goatham Memorial Trophy – Best exhibit of Bramley
44 The David Burd Memorial Trophy – Entrant with most points in all classes
85 The W Bruce Challenge Cup – Best exhibit of dessert apples excluding COP or any Sport in all Classes (Dessert apples, Exhibitor under 40)
Highest points
80 The Winch Memorial Challenge Cup – Exhibitor gaining the highest points total for Weald of Kent. Exhibits in all classes (restricted to exhibits grown in Kent, south of the M20 motorway)
81 The John Thwaites Challenge Bowl – Exhibitor gaining the highest points total for all exhibits in all classes (restricted to exhibits grown in Kent, north of the M20 motorway)
82 The Fiennes Cornwallis Trophy – Exhibitor gaining the highest total of points in all classes
88 The BIFGA prize – Exhibit gaining most points entered by a BIFGA member
89 The John Acock Memorial Rosebowl – Exhibitor with most points in culinary classes
45 Agrovista Regional Champion Cup – Grower with most points from Eastern Counties
46 Agrovista Regional Champion Cup – Grower with most points from West Midlands
Other prizes
83 The Cantagrians Association Cup – Best exhibit picked and packed by a former student of Hadlow College, KFI or KHI
91 The J R Breach Prize – Best entry of Nuvar™; Cheerfull Gold™ NC1; Stardance™ NC2; Cabaret™ NC3 or Misty Rose™
Classes 1-17 judged and displayed at the show
Each entry will consist of three 60cm x 40cm trays. Fruit to be selected at the stewards’ discretion for detailed examination by the judges.
Prizes:
Class and Perpetual Trophy (held for 1 year)
Class 1
Bramley 90-100mm diameter
The Alfred Shread Challenge Cup
Class 2
Bramley 80-90mm diameter
Squire Salver
Class 3
Any other variety of culinary apples 75-100mm diameter, with 5mm differential
Dufaylite Developments Cup
Class 4
Cox’s Orange Pippin or any Sport of Cox 70-75mm diameter
Systhane Cup
Class 5
Cox’s Orange Pippin or any Sport of Cox 65-70mm diameter
Vernon Hayes (Seeds) Ltd Challenge Cup
Class 6
Cameo 65-70mm or 70-75mm diameter
Cornwallis Cup
Class 7
JazzTM 65-70mm or 70-75mm diameter
Fuller Water Systems Trophy
Class 8 The Roger Worraker Class
Gala or any Sport of Gala 65-70mm or 70-75mm diameter
Pask Cornish & Smart Cup
Class 9
Russets: All varieties 65-70mm or 70-75mm diameter
Henshall Rose Bowl
Class 10
Magic Star 65-70mm or 70-75mm diameter
A R Piller Challenge Cup
Class 11A
Braeburn or any Sport of Braeburn 65-70mm
The WASP Bin Trophy

Classes 1-16 Open to All Growers
Prize Money for Class sponsored by

Braeburn or any Sport of Braeburn 70-75mm or 75-80mm diameter
The Horticultural Containers Wine Goblets
Class 12A
Any Other Variety of Dessert Apple introduced before 2013
Small fruited varieties 65-70mm or 70-75mm diameter
Large fruited varieties 70-75mm or 75-80mm diameter
George Harlow Cup
Class 12B
New Variety of Dessert introduced after 2013
Small fruited varieties 65-70mm or 70-75mm diameter
Large fruited varieties 70-75mm or 75-80mm diameter
Invicta Petroleum Shield
Class 13
Comice 70-75mm, 75-80mm or 80-85mm diameter
Ernest White Cup
Class 14 Conference 60-65mm or 65-70mm diameter
AMG Trophy
Class 15
Concorde Fruit must be 60-65mm, 65-70mm or 70-75mm diameter
East Kent Packers Cup
Class 16
Any Other Variety of Pear 60-65mm, 65-70mm, 70-75mm, 75-80mm or 80-85mm diameter
Segro Salver
Under 40s culinary class has been removed. Please enter your pears and culinary apples in classes 1-3, 13-16 as appropriate. Dessert apples may be entered in class 17 or any other dessert apple class. To encourage U40s’ entries the entrant does not have to grow the fruit, but must pick it and pack it themselves. U40s entrants are eligible for all the relevant championship trophies on page 3, as well as those specifically for U40s. The name and date of birth of the individual entrant must be completed on the entry form.
Class 17
Dessert Apples - Entrants under age 40.
Western International Market Shield for Dessert Apples
The Sue Daly Novice Trophy
Canterbury and Sittingbourne

EAST
Landseer Ltd will also award a special prize of £50 to the Store Operator of the Best Winning Entry. The Ron Tassell Trophy is awarded for the Store Operator of the Best All-Round Exhibit in the LTFS classes.
Class and Perpetual Trophy (held for 1 year) Prize Money for Class sponsored by
Class 22 Gala or any Sport of Gala
The Bloomfields Award
Class 23 Bramley
The John Wills Award
Class 24 Any Variety of Dessert Apple except Cox’s Orange Pippin or any Sport of Cox, Gala or Braeburn
Class 25 Cox’s Orange Pippin or any Sport of Cox
The Marks & Spencer Trophy
Class 26 Pears
Class 27 Braeburn
The Lambert & Foster Award


Class and Perpetual Trophy (held for 1 year)
Class 22 Gala
The Bloomfield Award
Class 23 Bramley
The John Wills Award
Class 24 Any Other Variety of Dessert Apple
Class 25 Cox
The Marks & Spencer Trophy
Class 26 Pears
Class 27 Braeburn
The Lambert & Foster Award
Ron Tassell Trophy for the Store Operator of the Best All Round
& Son J L Baxter & Son
Hinge & Son Moatlands Farm Ltd Adrian Scripps
Farm Northiam Farm Simon Bray
Son
Sponsored by
(1997 World Record 1.675kg Loddington Farm Ltd)
Sponsored by
Organised in conjunction with the Kentish Cobnuts Association and The Walnut Club.
Class and Perpetual Trophy (held for 1 year) Prize Money for Class sponsored by
Class 50 Kentish Cobnuts
Class 51 Cobnuts – any other variety
The John Bardsley Tankard for the Most Meritorious Entry of Cobnuts
Class 55 Walnuts - Eight nuts in their shells unbleached in each punnet. Open to commercial and amateur growers.
2024 has continued to be a year of challenge for growers but there are also the green shoots of opportunities starting to appear.
Recouping the inflation in costs that we have all seen over the last three years continues to be a challenge for growers with their supply chains. In addition, this year’s significant challenge has been the changes that Sedex wishes to make to the SMETA audit which have very significant potential economic consequences. To read more about the work BAPL has been doing to represent growers, please visit the BAPL website.
However, green shoots are emerging. We were delighted that AC Goatham & Son Ltd has struck a 20 year deal with Aldi. When a grower is planning investment in new orchards, it is a 20 to 25 year financial commitment. It is good to see Aldi recognising this timescale.


www.britishapplesandpears.co.uk/supermarket-sales-data/
www.britishapplesandpears.co.uk/supermarket-sales-data-pears/
Last year, we established British apples as a superfood, and we continue to promote the amazing health benefits of apples and pears.
The latest scientific research confirms that apples and pears really do pack a bigger than average nutritional punch. In fact, of 52 fruits and vegetables studied, apples and pears were in the top five of high-metabolic quality superfoods.
New season British apples will once again be the focus for many retailers in September and October. Look out for supermarket promotions, grower features, health facts and lots of social media activity throughout autumn.
Perhaps the most important job for BAPL is to speak up on behalf of our growers. Our messaging has been strong and consistent. We need fair returns from supermarkets, access to labour, workable audits and stronger support for home-grown, quality fresh produce.
We have invested time at Westminster and No 10 Downing Street this year to ensure that the voices of our growers are heard. We also work in partnership with other crop associations to create a louder voice for horticulture.
Now in its second year, our monthly sales data is driving real change in retailer attitudes. Everyone can see exactly which supermarkets are supporting British, and it’s creating some great competition as retailers strive to be top of our league table. We’re now publishing both British apple and pear monthly sales data on our website.
Our R&D team continues to ensure that our growers have access to the crop protection and innovation they need. In addition to contributing to Horticulture Crop Protection (HCP) Limited for EAMUs and EAs, BAPL’s own technical committee commissions vital top fruit research.
Current projects concern storage, scab, woodlice and biochar, including lifecycle carbon analysis. The results will continue to be shared with our growers.
Despite the challenges of recent years, we remain committed to our ambition to achieve 60% market share for British apples by 2030. We should be rightly proud of our industry for supporting domestic food security, the rural economy, our environment and the health of the nation. ■
As the fruit sector continues evolving and facing new challenges, whether from rising costs, labour availability, new pest/disease threats, or an increasingly limited chemical armoury, so the need to innovate and adapt has never been greater.
Hutchinsons is at the forefront of developing new solutions, that aim to drive productivity and sustainability, helping growers secure a more profitable future.
One major initiative is the 10-year HELIOS project, now in it’s seventh year, investigating whether orchard canopies and tree architecture can be redesigned to intercept more light and improve yields in a cost-effective, sustainable and ‘future-proof’ way. Two orchards of Gala Galaxy clones on different rootstocks have been established, in Kent and Gloucestershire, featuring different planting systems.
Hutchinsons agronomist Rob Saunders, who manages the Kent site, says one HELIOS configuration is already showing significantly improved profitability relative to industry-standard post and wire single row designs.
“While the pace of change for orchard designs has slowed, peak orchard productivity has not been reached. Future designs could look very different depending on the outcome of HELIOS.”
HELIOS trials also provide a testbed for other cutting-edge technology and techniques to improve orchard management and productivity. Below are some innovative projects Hutchinsons is involved with:
IRIS aims to improve the resilience of scab fungicide programmes in the face of a diminishing fungicide armoury. It is investigating whether biostimulants can help trees withstand disease and fill ‘gaps’ in spray programmes by triggering systemic acquired resistance. Twenty-two treatments were tested this season, with some showing excellent scab reduction.
Hutchinsons is working with partners to develop a novel system for detecting scab spores in the orchard to asses the correlation with RIMpro predictions. A cyclone air sampler collects spores, the DNA from which is analysed to identify those present.
The aim is to develop a fully automated system to provide growers with early disease warnings. Forty devices are being trialled in orchards in Kent and the West Midlands, plus eight in vineyards.
CRAFT, now in its second year, is investigating whether elicitor products, growth regulators, foliar feeds or biological fungicides can bolster natural defences of apple trees to infection by the Neonectria ditissima fungus, responsible for canker formation. “One treatment proved surprisingly effective in its first year of trials,” notes Mr Saunders.
The Innovate UK-funded project seeks to map orchard variability or detect disease with sensors, enabling variable-rate application of thinners, growth regulators and plant protection products.
It builds on an earlier Innovate UK-funded Precision Orchard Dosing System project that used winter LIDAR scanning to map tree height and density, before a drone-based blossom scan in spring.
Machine learning uses this data to develop variable rate plans for applying thinners and growth regulators through a purpose-built, highly accurate sprayer.
Mr Saunders says POME will improve orchard monitoring, allowing earlier disease detection, better crop estimation, more confident marketing, improved consistency, and reduced environmental impact.
Another Innovate UK-funded project uses sensors, AI and machine learning to detect and identify unique electronic impulses transmitted within trees in commercial orchards at times of stress (e.g. drought, pest, disease or nutrient deficiency).
The Innovate UK-funded project ‘Taking UK apple production to Net Zero’ examines biochar’s use for carbon removal. It concludes this year and a report will be published for the sector.
To meet the increasing demands for multi-faceted agronomy, Hutchinsons has significantly expanded its horticultural team, with eight new members in the past two years, supported by specialist environmental, soils, and digital services teams.
Tools such as TerraMap HD soil scanning, and Omnia – which includes exciting new developments within the latest upgrade – offer a real step forward for growers, allowing complete paperless record keeping and work management, alongside accurate mapping and management of crop performance variations to maximise output.
Discover how Hutchinsons can help your business at stand M20 ■

Hutchinsons Enhanced Light Interception Orchard System (HELIOS)
Having spent 2024 celebrating our 50th anniversary and 40 years as a Fendt dealer, as the year draws to a close, it seems fitting to be looking forward to ushering in a new era for the now one-day National Fruit Show.
There is little point in sugarcoating the current state of the industry.
The past few years have been particularly challenging for British growers, and now more than ever, orchard, vineyard and packhouse managers are assessing the costs of fruit production, looking to cut back and drive profits wherever possible.
Advancements in machinery and packhouse technology have undoubtedly relieved pressure on the costs of labour, and some specialist machinery is also helping to improve the quality of fruit and the percentage of class 1 fruits picked.

Claire and Nick Seymour

As we become more accustomed to using this machinery, thoughts in recent years have turned to not what is available but how to scale up and get more rows worked and treated in fewer passes.
Larger machines, however, require higher output tractors and thoughts then turn to upgrading the fleet.
When it comes to calculating the cost of ownership for tractors, the AHDB has an incredibly useful resource which requires a few inputs to generate the total cost of the tractor per year, per hour, and for the duration it is likely to stay on your farm.
While many growers often focus on the initial purchase price, the calculator demonstrates how important deprecation and the tractor’s fuel usage per hour are to the overall cost of ownership.

You are invited to join us on our stand at the National Fruit Show for fizz and cake to celebrate our 50th anniversary and 40 years as a Fendt dealer
To calculate the fuel usage costs per hour, Tim was recently invited, along with representatives from two other dealers, to attend a small trial conducted by a grower in Faversham.
Each fruit tractor started with a full fuel tank and was set up to operate the same 1.8 metre rotary topper for one hour at 6 km/h and approximately 1,700 rpm.
At the end of the hour, the amount of fuel required to refill the tractors was recorded. The Fendt required 5.1-litres compared to the other fruit tractor which finished the trial and required 7.6-litres. Due to a breakdown, the third tractor was unable to finish the trial, and so the data was left unrecorded for that machine.
When it comes to depreciation, Fendt is widely regarded as the best specialist tractor on the market for retaining its long-
term value, with growers able to benefit from higher-than-average resale or part exchange offers.
So, while Fendt might be known for its premium purchase price when taking into account the fuel cost per hour and the low deprecation, it offers a much more competitive long-term cost of ownership.
In fact, when pulling everything together, figures calculated using the AHDB “Tractor Costing Calculator” show that a Fendt 211V can save growers approximately £42,000 on the total cost of ownership over 10 years compared to the other two fruit tractors which appeared in the trial.
If you would like more information about the Fendt 200 V/F/P series, the trial we participated in, or our range of cost-saving, fruit-enhancing machinery, please visit us at the National Fruit Show. ■
The UK’s fruit industry relies heavily on the dedication and hard work of its workforce, including a significant number of overseas workers.
As a major sponsor of this year’s National Fruit Show, we understand the challenges growers face in ensuring their employees are paid promptly, accurately, and conveniently.
OnePay offers a streamlined payroll solution specifically designed for the agricultural sector. By providing a secure and accessible way for workers to receive their wages, we help to alleviate the pressures of managing a diverse workforce. Our prepaid card system eliminates the need for traditional bank accounts, making it easy for employees to access their earnings, both in the UK and when they return home.
But OnePay is more than just a payment method. We are committed to supporting the wellbeing of your workforce. Our user-friendly mobile app, available in multiple languages, empowers employees to manage their finances with ease. Our multilingual customer support team is always on hand to assist with any queries or concerns.
We recognise the importance of compliance and worker safety. As a service partner of the Association of Labour Providers, we adhere to strict industry standards. We also collaborate closely with law enforcement agencies to protect workers from exploitation.
Signing up for OnePay is simple and

cost-free. Our dedicated team can quickly set up accounts for your employees, even without immediate access to identification documents. This hassle-free process ensures a smooth onboarding experience for both you and your workers.
By choosing OnePay, you’re not only simplifying payroll but also demonstrating your commitment to the welfare of your employees. We invite you to visit us on stand M79 at the National Fruit Show to learn more about how OnePay can benefit your business and your workforce.
Let’s work together to create a more supportive and rewarding environment for your valued employees! ■

Do your workers struggle to open a UK bank account?
At OnePay we provide an alternative solution to pay your workers in a fast and secure way.
That’s why we offer you:
Simple set up for you and your workers
Dedicated account management support
A digital portal for easy worker onboarding and access to information
And for your workers:
An in-house multi-lingual customer support
24/7 account access via the customer app and portal
Use your OnePay card wherever Mastercard® is accepted








Discover how OnePay can support your business Visit us at Stand M79, or contact our Sales Team on 0113 320 1466





The Worshipful Company of Fruiterers has been in existence since before 1300 AD and stands 45th in order of precedence of the Livery Companies.
In its earliest days, The Worshipful Company of Fruiterers was a classical medieval guild governing the fruit trade, maintaining quality, training apprentices, caring for its members and doing other charitable works.
Despite the passage several 100 years these guiding principles haven’t really changed. The promotion of excellence across all sectors of the fruit industry and the provision of support for education and research within the industry remain among the Company’s core objectives alongside fundraising and giving to charity.
Through the Company’s Awards Council it invests in a range of activities to support the fruit industry.
The Company offers several awards to recognise outstanding merit and contribution to the industry. One of the highlights of our Awards programme is the David Hohnen award which is given to a student who has undertaken an outstanding piece of work to further the interests of the fruit industry in the UK. Further information about the David Hohnen prize is available at www.fruiterers.org.uk/awards
The Company also supports the Nuffield Farming Scholarship programme. Our latest Nuffield scholar, Polly Hilton is researching opportunities to improve
the quality of fine cider produced in the UK and how the industry can better communicate its messages around quality and its green credentials.
Industry research is another area where the Company is active in providing financial support and this year it is funding research into the impact of climate change on bumble bees.
Other projects which benefit from the Company’s charitable work include the Collaborative Training Partnership, the LSA Fellowship Scheme and the Plum Demonstration Centre.
For more information about the Worshipful Company of Fruiterers, its work and its industry awards please go to www.fruiterers.org.uk
The Wo 1300 A In its ear maintai Desp haven't r fruit indu the i Through The C contribu is the D an outs the UK The Com a v

Cindayniah Godfrey, a Fruiterers award winner presented at last year’s show

New Spitalfields Market is the premier fresh produce wholesale market in the UK, serving all the London boroughs and beyond into the Home counties of Kent, Surrey, Sussex, Hertfordshire and East Anglia
This year in support of the National Fruit Show we are sponsoring the Bonanza Prize and would like to invite the winner to have an early morning tour of the market with a stay at a local hotel with dinner included.

New Spitalfields Market procures its produce globally from all corners of the world, but is always proud to support the UK growers throughout the year and at the height of the summer season its sells a large percentage of good quality home grown food.
It boasts over 100 independent businesses, all procuring and selling fresh produce to its constantly expanding customer base. The history of the market goes back centuries to the area within the City of London boundaries where is was based close to the Spital area of the City, or hospital as it is historically recorded. Fresh Produce has always been a valued part of a healthy

diet and since 1926 The City of London have been proud to be the landlords to this historic and iconic market, keeping its local community well stocked with fresh produce.
Since 1991 it has been located to the eastern side of the City, and close to the main arterial routes into London. Its geographical position is perfect for deliveries and redistribution. With good links to the ports on the east coast and the Tunnel at Dover, produce is procured daily from the UK and European hubs and within 24 hours can be replenished with more freshly sourced goods.
It really is the world under one roof for the fresh produce industry. ■











Mark and Stephen Tully and Catrin Allen, Landseer Ltd report on huge strides in post-harvest storage of top fruit that delivers for growers and consumers.
Over the past few decades, technological advancements in storage techniques and increased knowledge have significantly extended the storage capability of top fruit while substantially reducing waste, that’s an estimated 40% improvement. These innovations ensure that consumers have access to high-quality British top fruit for much of the year. Looking ahead, continued developments look for even greater efficiencies and extended availability of UK top fruit.
Once harvested, fruit enters its postharvest life, which can be just as long—or even longer than the time the apple spent attached to the tree. This is of course nothing new as we have been storing English fruit for nine months since the 1930’s; we have just got better at it. This requires attention to detail to ensure that apples maintain their ‘just-picked’ crunchiness and flavour. The primary focus should be on cultivating the highest quality produce in the orchard. Ensuring optimal nutritional levels and balance throughout
the growing cycle is essential to give the fruit the best chance of maintaining its quality post-harvest. Disease control in orchards is also crucial for reducing storage issues.
Another useful indicator of apple storage potential is Dry Matter, which includes all the solid components of the apple such as sugars, acids, fibres, vitamins, and minerals once the water has been removed. Traditionally, measuring dry matter has been a laborious task. However, with advancements in technology and improvements in accuracy, it is now possible to non-destructively measure the dry matter of fruit directly on the tree, allowing for repeated measurements of the same fruit. This capability enables growers to rank orchards in the build-up to harvest and start to maximise storage potential. Additionally, fruits with higher dry matter that are picked on time – before significant starch conversion has begun (around 70%) – tend to have a higher sugar conversion during storage to reach higher brix levels.















When it comes to picking, maturity testing for each variety is essential to ensure optimal picking time. Balancing the varying requirements of different varieties, especially premium club varieties that take priority due to their higher value, can be challenging. Maintaining good hygiene and careful management to prevent bruising is essential during this process.
In the UK, we are increasingly experiencing variable weather patterns, from one extreme to another. These extremes can disrupt the continuous movement of nutrients throughout the plant and its fruits. The use of stepwise cooling as the fruit enters into the store is the best way to make the transition from field to store and cause the least amount of stress to the fruit. For successful storage the most important factor is reducing the fruit’s temperature, as apples follow the Q10 coefficient rule, where a 10°C reduction in temperature halves respiration rates. This is especially so during warm harvests – it’s vital to get the fruit down below 10°C before its slower transition to its long term storage temperature. The development of Controlled Atmosphere (CA)
storage conditions – regulating oxygen, carbon dioxide, and nitrogen levels – helps slow the natural ripening process. For some varieties technologies can be deployed to let the fruit decide on which level of oxygen it is happy with. This has various names the most common of which is dynamic controlled atmosphere (DCA). Depending on the year and variety, different storage regimes are followed to achieve the target conditions, ensuring the longest possible storage potential for the fruit.
Apples are climacteric fruits, meaning they naturally produce ethylene – a ripening gas – as harvest approaches. This ethylene production signals abscission, allowing the fruit to detach from the tree and facilitating seed dispersal (evolutionary process) by weakening and breaking down cell walls. However, excess ethylene can cause disorders such as superficial scald, external browning, and loss of green background colour, depending on the variety. When loading a store efficiency and speed of how it is filled is crucial, ideally within three days depending on the store’s size, to prevent ethylene build-up.




Once all the fruit is in storage, the destructive effects of ethylene can be controlled by the application of SmartFresh. This works by preventing ethylene from binding to its receptor sites, thereby halting the ripening process and maintaining high fruit quality. When the fruit is removed from storage, its respiration rate naturally increases as the temperature rises, and apples begin to produce new ethylene receptors. Untreated fruit, lacking this ethylene management, is more susceptible to rapid ripening processes.
Developments in post-harvest hardware and software are enabling growers to continuously monitor their fruits in storage, providing real-time data to optimize store management and reduce waste. Some of these hardware advancements may include non-destructive quality and internal testing, digital fruit sizing and quality sampling before storage, sensors
measuring respiration during storage, and gas analysis for ethylene measurements in storage atmospheres along with developed software’s for this. Additionally, the use of artificial intelligence in analysing sensor data and agronomic information from the season – into a single platform ensures that the stores are opened to maximise consumer satisfaction. This comprehensive approach allows for the most efficient and informed decisions regarding store opening and fruit management.
By integrating developing technologies with the extensive knowledge and experience of growers and industry experts, the UK can significantly enhance the storage potential of its fruit. This approach will enable a longer supply of locally sourced, sustainable UK fruit to retailers, reducing reliance on higher carbon imports and supporting a more selfsufficient UK food system. ■






Just over 34 years ago, Colin Bird embarked on a job that he had no idea if he would enjoy it, or even if he could do it. He shares his memories.

Having just left farm management, I had in my former life dealings with several agronomists, so I knew what they were doing for me. As I quickly found out once I was let loose to do the job, different growers required different things from their support network.
As I look back, it is not a job, nor a vocation. You remain for some, a supply rep, others an integral part of their decision making, a confidant, a shoulder to cry on. Empathy during the bad times. Frost, hail and storm events litter my memory. I became friends with many and realised early on that you cannot help but get involved on a personal as well as professional level. Agronomy is not for the faint hearted, but it can be



Colin Bird
The best way to be a good agronomist is to look after the crop. Balance is the key. Regular cropping does not happen by accident. Nutrition, growth control and thinning are all important, but growing the right crop on the right site with the correct system will help make life easier. New thoughts and techniques from abroad need to be evaluated before being adopted as the weather conditions are different from even close countries like the low countries. I have seen too many failures where believing the hype has cost dearly. To this end I was instrumental in setting up the Agrii iFarm based at EMR, where we trial new chemistry, evaluated techniques and compared treatment efficacy along with training systems etc, to ensure Agrii advice is as accurate as possible.
Now at Agrii, I have been through six changes of ownership but never left my original company, served with many managers and worked with quite a few colleagues and customers, taking on extra roles and responsibility throughout my career.
One manager, Martin Howells, who was a great supporter of the NFS instilled in me the need to put something ‘back in the pot’ and as part of my journey, encouraged me to join the committee to offer support. Many chairpersons later (see, I am modern) having served both on the general committee and sub-committees as required and joining the trustees to aid in a small capacity, I leave the running of the Show in capable hands.
The society has faced difficult times in the past as well as good times. Putting on professional shows and educating the youngest members of society with school and show visits. There were times where new things were tried. Pumpkin competitions, (which I technically won with a perfectly matching pair of miniature pumpkins, but declined the honour there should be a picture of this in the show annals), tomato stands, introducing soft fruit competitions. International speakers and high ranking politicians, after show events etc, all to promote the best of British fruit growing and the issues facing the industry.

Agrii fruit agronomists don’t just advise on the best crop protection treatments; they can also help with the supply of a wide range of ancillary products as well as agronomy, regulatory, environmental and budgeting support services that today’s growers demand. The Agrii fruit team is comprised of dedicated top and soft fruit agronomists together with ancillary product specialists.

Julian Searle Agronomist & Viticulture Specialist

Neil Obbard Agronomist, South and South East

Ryan Williams Agronomist, Kent & Anglia

Ben Brown Agronomist & Viticulture Specialist

Richard Killian Agronomist, South East

Jonathan Garratt Agronomist, East Anglia

Matt Greep Area Business Manager Fruit & Agronomist

Jason Steels Agronomist, Lincolnshire

Steve Masters Product ManagerAncillary Products

Gary Saunders Agronomist, Kent

Emma Smith Agronomist, West Midlands

Matt Curry Commercial Support - Ancillary Products
The people who have served to ensure the success of the society and the shows are too numerous to mention after 34 years. But without the steadfast support of the volunteers, leadership, management, staff and industry support, the society would not be where it is today.
Having the iFarm producing fruit enabled Agrii to enter the NFS fruit show competitions with both apples and pears, where we held our own with the best in the industry. I won’t miss the hours spent picking and preparing the show fruit. Kudos to the stalwarts who commit many days preparing the show fruit, which is and hopefully remains at the heart of the show.
One of my personal highlights is the 70th anniversary show in 2003 where the UAP personnel, as we were then, dressed up as farm workers from that period with a show stand to match. Since then, as the show has grown, the number of top fruit growers
has shrunk dramatically. The growers that remain, are highly professional business people, working with difficult parameters to maintain profitability. The days of 1933 are gone, along with the romance of the time, when a few growers in the Marden area got together for the first time to compete against each other to see who grew the best fruit.
Working outside, rather than an office was always preferable, seeing nature up close and revelling in the diversity of nature. Early on in my life I sat on a tractor watching two stoats playing in an orchard, and watching starling murmurations as they go to roost. I still set my calendar by nature. When the first butterflies emerge, normally March, the call of the cuckoo in April, the arrival of migratory birds from the southern hemisphere or when catkins appear on the hazel platts. Looking back, you forget when you last saw the lapwings in an arable field, one of the heralds of Spring.


















Saturday 9th November 2024
10:00 am - 1:00 pm
Saturday 25th January 2025 10:00 am - 1:00 pm





















Pre-register at hadlow.ac.uk/events








































































































































































































































Now we are into looking after nature and encouraging biodiversity in the fields. Maybe improvements can be done, but there is a long road to walk with perils and pitfalls aplenty. Introducing nature into growing environments will have as many adverse effects as well as benefits.
Remember to inspect, evaluate, introduce and observe. Remember, do not believe the hype without testing it first. I still do not want a rotting strawberry or a maggot in an apple. Customers will buy with their eyes first.
The top fruit industry is in a period of reset and I am sure will emerge with a slightly different complexion capable of competing in the times ahead. Just look at where the vineyards have got too now from the humble beginnings of small individual units dotted around the country. In that time there were many less commercial units, run part time, unfortunately producing some mediocre wines, possibly because they were trying to emulate the French way of wine production. Even then, the English Bacchus produced a very good glass. Now we have award winning wines and consistency to compete globally.
I have seen the soft fruit enterprises grow exponentially producing volumes of fruit per

hectare, unheard of when I started out. That said, walking tunnels was not my favourite past time on a hot sunny day.
I shall miss being around as much, but my knees will be happier. ■
























































































We started the year with a great change within the Education Team, as the founder of the programme Samantha Smith moved onto pastures new. We would like to wish Samantha well and we hope to continue her good work.
The popularity and the need for our programme seems to grow every year. This expansion is forever growing to meet industry and education needs. The fundamental goals for this year have been to build greater partnerships with industry and education. As Education Officers our own knowledge must diversify and expand within an industry that is dynamic and forever changing.

Research over this year has shown the gap between the curriculum in schools and the careers on offer within the industry. At the Teacher Encounter during last year’s National Fruit Show, the teachers expressed that they found it hard to link subjects to the industry. But after visiting the show it helped them understand how industry offers a diverse range of careers for everyone.
Our secondary workshops and careers events link what they are learning in school to how it can link into careers. The handson workshops for secondary schools look at quality control, agronomy and landbased engineering.
We are currently developing a breeding and DNA programme in conjunction with Growing Kent & Medway and NIAB. These programmes are to promote the industry, but will also help guide the young person before they choose their options in school and we hope fill the shortfall of young people coming into the industry. Industry is key to supporting us through this initiative as these are not just future consumers but our future workforce.


The education team have been very fortunate to have been invited to AC Goatham, Avalon, Brogdale Collections, Growing Kent & Medway, NIAB, British Independent Fruit Growers Association and City Harvest. These visits have enabled us to understand first-hand what industry are doing and take it directly into classrooms. As you can imagine trying to get 10,000 young people on a farm or to the National Fruit Show would be beyond challenging! Our education team can deliver these links on the road or in a classroom.
Examples of learning from the industry: During our visit to A C Goatham’s, Flanders Farm we toured the whole operation. We saw the journey of an apple from the cold store to the final product packaged, ready and loaded onto the lorries for the onward journey. The visit showcased the variety of technology used within the industry. Avalon’s, Nigel Jenner has been very supportive, sharing his knowledge and has hosted us on farm to develop our Quality Control workshops and is always willing to answer any questions we have.
The Brogdale visit saw us touring the National Heritage Fruit collection and making links with their education initiatives, so we can hopefully work together in the
future to develop joint programmes. At our visit to East Malling to spend time with Growing Kent and Medway and NIAB we discovered the latest developments in apple breeding and DNA. Now a new programme is under development in this area and support from them both is playing a major part in the materials we use. BIFGA very kindly invited us to their farm walk, which was very informative and provided networking opportunities to meet growers and explain the work we do.
Our most recent visit was to City Harvest to see the impact of the re-distribution of food that would otherwise be sent to landfill. This showcased how re-distributing food has a major impact on the communities who receive the donations whilst helping businesses to become more sustainable. The Education team already centres a large portion of our teaching around issues like food waste and Carbon Footprint, so this gives us more in-depth knowledge how this subject can be tackled. The work done by this charity is inspiring and heart breaking at the same time, it’s shocking to think that in this day and age there are people really struggling to provide enough food for themselves and their families. City Harvest is now offering meals as an extension of help for wellbeing.


The 2023 - 2024 academic year has been another successful year for the team interacting with just short of 11,000 young people and families. This is achieved by delivering educational workshops, attending careers events and agricultural shows. Our year so far has seen us travel to many different events as well as our day-to-day school programs.
We have visited a variety of schools including nurseries, primary, secondary, special schools and alternative provision schools. We have also expanded the sessions to include uniform groups. Our core workshop covers the year in the life of an apple tree, tasting two varieties of apples, apple crisps, fruit leathers and the young people to make their own apple juice. Frank P Matthews donates a tree to each school we visit, this gives the young people the opportunity to experience the life cycle of the tree and the care it requires in order to grow.
We have been contacted by a number of large agricultural societies that are helping us with sponsorship to attend their events as they see what we are doing as important and want the message to be delivered to their visitors.
We are now seasoned visitors to Living Land and the Kent Show (Kent Agriculture Society), Countrytastic and Malvern Autumn Show (Three Counties Agriculture Society). We visited Countryside Days (Yorkshire Agriculture Society) for the first time this year.
Countryside Days is held over two days and is aimed at schools. Schools book to attend and the Yorkshire Agriculture Society allocate the schools for a variety of workshops to attend which enables children to experience and explore all
aspects of food, farming, the countryside and healthy living. We felt very privileged to be approached to attend this event and it turned out to be a very full, fun packed two days. In fact, Mandy had so much fun she almost lost her voice (something that is unheard of normally). We received a lovely message from the society even before we reached home
“On our walk round at the show, it was so lovely to see The National Fruit Show stand looking fabulous in a blaze of red within the hall, but most importantly how engaging, inclusive and fun the sessions were. Lots of the children saying it was their favourite activity. Can I just thank you ladies for taking on extra students when another exhibitor didn’t turn up and how amazing it was you had over 60 children fully engaged with ease at one point during the day”
To sum up we have had an amazing year and have discovered the programme needs to expand further to ensure we are covering the needs of the industry. Obviously, we cannot do this without the support of the industry or sponsorship. We would really like to thank all that have sponsored, given up time to talk to us, volunteered and basically just listened to why we think education is key to future of our industry.

Due to the current financial climate, we are seeking grant applications and sponsorship externally to the National Fruit Show to help us expand the workshops further.
Thank you to following for all they contribute as without them the programme would not be able to run:
• AC Goatham
• Avalon
• Berry Gardens
• Certis Beltrin
• Collingwood Fruit Farm
• EC Drummond
• Frank P Matthews
• Hutchinson Charitable Trust
• Nims Crisps
• One Pay
• Wye Fruit ■
Sponsorship
Time
Equipment
Experience
For more information speak to a member of the Education Team or email education@nationalfruitshow.org.uk
As a major sponsor of this year’s National Fruit Show, we understand the challenges growers face in ensuring their employees are paid promptly, accurately, and conveniently.
As a leading provider of payment solutions for the agricultural sector, OnePay is committed to making your life easier while also ensuring the wellbeing of your workforce. Our dedicated client services team is here to assist you at every step of the way.
Unlike other payment providers, OnePay understands the unique challenges faced by agricultural businesses and their workers. Our Client Services Team is always ready to answer your questions and address any concerns you or your workers may have. We can also provide personalised support to your workers directly in multiple languages via our Customer Services Team.
We recognise that your time is valuable, that’s why we’ve designed our services to be as efficient and hassle free as possible. As well as your own requests, our team can also process requests that you make on behalf of your workers.
At OnePay, we are dedicated to giving back to the agricultural community. We are very proud to be major sponsors of

the National Fruit Show and we have also been supporting the National Fruit Show’s education programme for the past four years by sponsoring their van “Blossom”. Blossom travels with the team across the country visiting schools and other youth group, educating the next generation on the importance and diversity of the agricultural industry.
Visit us on M79 stand at the National Fruit Show to learn more about how OnePay can benefit your business and your workforce. ■


Agrii is the UK’s leading supplier of agronomy and farm support services, with over 300 BASIS-qualified consultants working with farmers and growers across England, Wales, Scotland and Northern Ireland.
Independent advice is backed by a robust research and development (R&D) programme that trials Agrii’s products and services, giving customers confidence that they are working with a reputable and forward-thinking business.
Agrii is actively preparing for the future of UK fruit production by focusing on sustainability, innovation and technologydriven solutions. This initiative aligns with government regulations and consumer pressures for more sustainable food production and aims to future-proof farms against climate challenges and market demands.
Agrii’s research and development efforts are central to this forward planning. It
invests in new crop protection products, advanced integrated pest management (IPM) techniques and precision farming technologies to enhance yields while minimising environmental impacts.
As the gradual withdrawal of plant protection products continues, it is Agrii’s commitment to R&D, working alongside partner manufacturers and research stations, that will overcome these challenges and maintain a strong armoury of products for fruit-growing customers.
Agrii’s horticultural agronomists are expert advisors with years of experience and have worked with generations of fruit growers across the UK. Collectively, they are best placed to provide marketleading advice while supported by a coordination team that offers unrivalled customer service. With distribution depots from south Devon to east Kent and from Hampshire to Perthshire, Agrii offers UK-wide coverage for speedy and reliable delivery. ■
Success set to bloom at Kent’s first Centre of Excellence in greenhouse growing.

Hadlow College, Kent’s only rural and land-based college, is inspiring the next generation of horticulturists after the UK’s first centre of excellence in greenhouse growing was opened on the site this summer.
The Thanet Earth Centre of Excellence @ Hadlow College is a groundbreaking partnership between the college, leading industry grower Thanet Earth and research and innovation organisation Growing Kent & Medway.
The facility at Hadlow’s state-of-the-art glasshouse allows horticultural students to benefit from working directly with Thanet Earth, the UK’s largest glasshouse salad
supplier, to develop their skills and grow tomatoes in a commercial crop environment.
The centre of excellence plays a central part in Hadlow College’s wide range of horticulture courses, with students also benefitting from a ‘concept orchard and vineyard’ which features automated AI management systems, innovative crop diversity and robotic fruit picking.
To find out more about the college’s horticulture courses and see these topclass facilities first hand, come along to the Hadlow College open event on Saturday 9 November, from 10am to 1pm.
To register visit www.hadlow.ac.uk ■
Targeting the fruit crop with available nutrients exactly when they are needed is fundamental. This means that highquality fertiliser products are required, linked to crop knowledge and application competence. These two aspects together mean Yara can help to support high productivity for growers with minimal environmental impact.
Yara has developed many tools and services to help share its knowledge concerning optimising yield and quality. In-depth crop knowledge is fundamental in selecting the right product package and applying the correct amounts as well as understanding the best time to apply for the developing crop.
We believe that targeting the fruit crop with readily available nutrients exactly when needed is fundamental. Come and talk to us and see how Yara’s high quality fertiliser and fertigation products can help you grow bigger and better next season.


Landseer Ltd specialises in crop protection and horticultural advice, with over 40 years of experience in the fresh produce industry.
The company is known for providing cost-effective solutions, particularly in post-harvest services, and employs a team of industry-recognized experts, including BASIS-certified professionals, FACTS advisors, researchers and qualified crop protection applicators.
Key services and products offered by Landseer include acting as marketing agents for Corteva Horticultural Crop Protection products in the UK and actively participating in product trials involving biostimulants. The team also manages AgroFresh Inc. services, such as SmartFresh™ applications, Strella,
Are you looking for help to combat nutrient deficiencies?



We believe that targeting the fruit crop with readily available nutrients exactly when needed is fundamental. Come and talk to our Fruit Specialists and see how Yara’s high quality fertiliser, fertigation and stimulant products can help you grow bigger and better next season. www
Tracy Beilby
Tracey Beilby 07768 598122
07768598122
tracey.beilby@yara.com
Our advice for farmers means that fruit yield quality can be maximised without losing nutrients to the soil and therefore impacting the environment. By selecting the correct product at the right time for the crop, YaraTera, YaraLiva, YaraMila and YaraVita products can help growers achieve maximum yield and quality in an environmentally conscious way. ■
tracy.beilby@yara.com
FreshCloud™ and non-destructive fruit testing alongside storage consultancy and fruit monitoring, backed by a robust database built over years.
Landseer is also involved in innovative industry technology, such as distributing Trapview automated pest monitoring devices and providing comprehensive monitoring services, including trap maintenance, lure changes and weekly updates. The team is also committed to providing accurate and automated sizing technology tailored to UK-specific needs. It is also involved in developing an early disease detection system using hyperspectral imagery in collaboration with Innovate UK.
For more information, see www.landseerltd.co.uk or visit stand M77 at the National Fruit Show. ■
Hortifeeds is excited to welcome visitors to the National Fruit Show on 6 November at the Kent County Showground.
Alongside our team we are pleased to introduce Rob Kempster, lead applications scientist at Plant Impact, who will be available to discuss the benefits of Amētros, the leading calcium mobility product. Amētros has been shown to enhance Class 1 yield and improve fruit firmness across a
variety of fruit crops, making it a valuable addition to any crop fertiliser programme.
Hortifeeds will also be highlighting the advantages of regular applications of our complete biostimulant, HortiBoost. When used in tank mixes with programmed sprays, HortiBoost improves fruit quality and yield while also strengthening plants to resist stress factors such as extreme heat and drought. The ‘little and often’ application method makes it a cost-

effective way to protect crops year-round.
Hortifeeds will also be showcasing its extensive range of fertilisers and biostimulants, including foliar products suited to all fruit crops and growth stages, as well as bespoke soluble fertilisers for both top and soft fruit.
Visit stand M47 to learn how Hortifeeds can help improve your crop fertiliser programme or see www.hortifeeds.co.uk ■
Jenco Renewables is a trusted partner for sustainable energy solutions in Rye and the surrounding areas. With a strong commitment to environmental responsibility and energy efficiency, Jenco offers expert solar panel installations, helping homeowners and businesses reduce energy costs while lowering their carbon footprint.
The Jenco Renewables team of certified professionals specialises in designing and installing high-performance solar systems tailored to each customer’s specific needs. Whether it’s to power a home, business, or a larger facility, Jenco Renewables ensures a seamless process from consultation to installation, with a focus on long-term energy savings and sustainability.

Controlled Atmosphere Services Ltd was established in June 2022 in recognition of a need to continue to support customers, friends and colleagues within the farming and fresh produce industries.
CA Services was started by Trevor Underdown, who was quickly joined by William Underdown and Andrew Cottam.
As a group of like-minded, customerorientated engineers with over 50 years of CA experience between them, the threestrong team is driven to give the best service and support to customers.
They pride themselves on delivering exceptional customer service and using high-quality materials and cutting-edge technology to guarantee every system operates at peak efficiency for years to come. The company’s mission is to understand the unique needs of its clients and it is dedicated to making clean energy accessible and affordable for everyone.
With that in mind, the company felt it was important to progress quickly into producing its own control systems.
CA Services currently has eight of its new scrubber controllers fitted in Van Amerongen CO2 scrubbers and two new CA control systems fitted as part of new installations undertaken by the company this year. Both can be viewed on stand M78 at the National Fruit Show.
The systems were designed, developed and built in house and with bespoke systems programmed by Derek Wilson, CA Services’ programmer and controls expert. ■
Take control of your energy future with Jenco Renewables and enjoy the benefits of solar energy along with lower energy bills, increased property value and a cleaner planet. Contact Jenco Renewables today for a free consultation and join the growing number of home and business owners making the switch to renewable energy. ■

Celebrating his 90th year, David Banfield



John Guest receives a Notable Contribution to the Fruit Industry award

Best Machinery Stand























BAPL research and development activity.
British Apples and Pears Limited (BAPL) is now in its second year of directly commissioning research to help top fruit growers with the challenges of pests and diseases.
In that time, BAPL has focused on priority pests and diseases as identified by the BAPL technical committee with support from agronomists in the sector. We have commissioned a multi-target integrated pest and disease management project based
at NIAB and a second project focussing on woodlice, undertaken by ADAS.
In addition to directly commissioning research, BAPL also applies for grant funding to supplement the income from

grower subscriptions. For example, BAPL was involved in a project aiming to minimise the cost of cold storage without compromising fruit quality which was led by AC Hulme and Sons with lead researcher Richard Colgan at NRI. This was funded as part of the Growing Kent and Medway ‘Business Sustainability Challenge’.
BAPL also successfully led a consortium to apply for over £480k of Innovate UK funding for a project titled ‘Taking commercial apple production to Net Zero’. The project has been busy evaluating the apple supply chain and its implications for the environment. Results are expected this year, and they will be presented via an industry-facing report at project completion.
To compliment these research projects, BAPL also works closely with Horticultural Crop Protection Limited (HCP). In 2023, efficacy trials were commissioned to look for crop protection products for scab control, with the intention of applying for EAMUs.
In 2024, efficacy trials are being conducted to look for products with efficacy against European apple canker. All products have been chosen with advice about their likely regulatory success from Carlos Duarte at HCP and their likely efficacy from Alex Radu at Agrovista who is one of the agronomist advisers on the BAPL Technical Committee. The BAPL technical committee also helps HCP identify gaps where EAMUs and Emergency Authorisations are needed and, when products are identified, the committee approves the required BAPL budget to pursue the authorisations.
BAPL will also co-fund projects when there are suitable opportunities to do so. In 2024, the most promising of the scab products which were identified in the 2023 efficacy trials which were funded by BAPL and managed by HCP have been taken forward

into a project with the aim of creating a ‘scab control programme’. This work is being conducted at NIAB and has been cofunded with a Business Innovation Voucher from Growing Kent and Medway.
BAPL intends to make further grant applications in 2024. If any members are interested in being involved in any of these research calls by suggesting ideas or hosting trials, please get in touch at research@britishapplesandpears.co.uk as grower involvement is vital to the success of these projects.
The research findings from all these projects were shared at the BAPL technical day in January 2024. If you missed this event, the presentations can be found on the BAPL website and the full reports from the projects are available to BAPL members on the BAPL website.
All the results from the 2024 BAPL research will be shared during a combined Tree Fruit Day hosted jointly by NIAB and BAPL on 10 February 2025. We hope as many as possible in the industry will join us. ■
NIAB’s Scott Raffle and Feli Fernandez review the history of apple rootstock breeding at East Malling, and how the most recent release M.200, offers the industry higher productivity and tolerance to disease.
Research at NIAB’s East Malling site has been synonymous with rootstock development since the site was first established in 1913.
The very first director of the then Wye College Fruit Experiment Station established a programme to study factors affecting growth and yield, and in
particular the influence of rootstocks on tree growth. This led to the collecting and characterising of previously commercialised apple rootstocks from UK and continental nurseries; followed by the propagation and release of distinct selections with welldefined effects on precocity and vigour of tree growth, including M.9 (dwarfing). These first releases and subsequent ones

derived from breeding at East Malling such as M.26 (semi-dwarfing) and M.27 (verydwarfing) were grouped under the Malling (M) series label. The Malling/Merton (MM) series, developed jointly with the John Innes Institute -then located at Merton Park (Surrey) and now known as the John Innes Centre (Norwich) – aimed to produce rootstocks suitable for overseas territories such as Australia and South Africa where woolly apple aphid (WAA) was, and still is, a major problem.
Rootstocks from both series have been adopted in all apple growing regions across the world. M.M.106 (semi-invigorating) was probably the most popular of the Malling Merton series; it is still grown commercially (e.g. in cider orchards) but is progressively being replaced by other rootstock of similar vigour and better disease resistance (e.g. M.116). M.9 has been the most widely-used apple rootstock both in the UK and across the world. Its dwarfing nature changed the way that apples are produced enabling higher density orchards to be planted and xqharvesting. Virtually all dessert apples grown in the UK are still grafted onto M.9 but, to remain competitive, growers increasingly require slightly more vigorous and robust rootstocks with better pest and disease resistance.
The East Malling Rootstock Club (20082020) was a commercial partnership with INN (International New varieties Network) and AHDB (UK grower levy board). It was set up to continue the evaluation of a pre-existing pipeline that had been developed with a focus on orchard and nursery performance and the generation of new breeding populations with a strong focus on pest and disease resistance. With climate change in mind, we aimed to select and breed rootstocks more tolerant of extreme weather events such as drought or waterlogging, whilst also identifying
resistance to insect pests and pathogens. Those biotic and abiotic adaptation traits are needed in combination with other factors including ease of propagation, a commercial vigour range of between M.9 and M.M.106 (Figure 1), and higher yielding than those of other available rootstocks. A slight increase in vigour is needed by some growers who have to plant on soils previously used for apple production and which might suffer from apple replant disease. Organic growers also need greater vigour to compensate for a more complex nitrogen supply or greater weed control constraints.
Early work at East Malling on the relationships between anatomy and rootstock vigour enabled early screening of seedling material in the rootstock breeding programme. Whilst very labour intensive, this marked an important beginning in the process of shortening the historic ‘wait and see how the plant turns out’ approach to plant breeding. By investigating the anatomical basis, and later the physiological and genetic basis of the traits and attributes targeted in a breeding programme, research teams at East Malling and other programmes have aimed to speed up the long cycle of releasing a new rootstock.
Historical public-funded projects and recent PhD studentships at East Malling have developed a range of laboratory and genetic resources allowing us to identify DNA regions (markers) associated with traits of interest to the industry and therefore targets for selection by breeders such as dwarfing, crown rot, woolly apple aphid and canker resistance. Using those markers and others developed by researchers elsewhere to preselect parents and seedlings before the traits can be observed in the plants themselves, is part of NIAB’s strategy for ‘markerassisted breeding’.
In combination with work from other research at NIAB (i.e. fast/speed breeding), marker assisted breeding enhances our ability to breed varieties with improved quality traits, whilst reducing the time it takes us to identify the elite progeny arising from a conventional cross made by the breeders.
However the most recent release from the programme at NIAB at East Malling, M.200, was developed in the most ‘conventional’ of fashions. The seedling was pre-selected as dwarfing, based on root anatomy in the 1970s following a cross made in 1971 between Robusta 5 with Ottawa 3. M.200 has been extensively tested both in the UK and in continental Europe for over 20 years including recent trials at two sites in France, one in Germany and one in Italy. It is also part of an ongoing rootstock trial run by the EUFRIN group in 12 European countries.
On average, M.200 is 35% more productive and 15% - 20% more vigorous than M.9 – with some variability seen between different sites and scions – producing a similar profile of fruit size ranges. Trees worked on M.200 (Figure 2) show a seamless graft union creating a very stable tree and, to date, they have performed well on replanted soils in continental Europe. It appears to offer a better range of tolerance than M.9 to a range of diseases.
Whilst not fully resistant, M.200 is more tolerant than M.9 to crown rot (Phytophthora cactorum), apple canker (Neonectria ditissima) and fireblight (Erwinia amylovora). It is also easy to propagate and we look forward to seeing established UK orchards soon. At present, M.200 can be ordered through the French propagator Dalival. ■

Do you want to increase the yield and quality of your crop?

Are you looking for help to combat nutrient deficiencies?
Do you want to increase the yield and quality of your crop? Are you looking for help to combat nutrient deficiencies?
We believe that targeting the fruit crop with readily available nutrients exactly when needed is fundamental. Come and talk to us and see how Yara’s high quality fertiliser and fertigation products can help you grow bigger and better next season.

We believe that targeting the fruit crop with readily available nutrients exactly when needed is fundamental. Come and talk to our Fruit Specialists and see how Yara’s high quality fertiliser, fertigation and bio stimulant products can help you grow bigger and better next season.






NIAB’s Matevz Papp-Rupar and Scott Raffle outline the severity of the problem and explain the ongoing journey to develop novel approaches to apple canker control.

Ask any UK apple grower to name their most pressing crop protection problems and they are sure to include apple canker (Figure 1) at the top of the list. NIAB and other scientists have been researching Neonectria ditissima (the cause of apple canker) for many years, but the reduction in numbers of authorised fungicide products has drastically increased the urgency to find novel approaches to control.
The incidence of canker developing in newly planted orchards has increased, particularly in very susceptible varieties like Gala planted in high density fruit wall systems. It is not uncommon to see 10% of trees dying each year in the first three years after planting. This incurs additional costs to replace dead trees, reducing yields over the life span of the orchard, and making orchard management more difficult due to low orchard uniformity. Neonectria ditissima also gives rise to fruit rots, which develop during the storage period. Control has become more difficult through the loss of available fungicides for the protection of potential sites of pathogen entry such as leaf scars, pruning wounds and picking wounds.
Good orchard hygiene is essential to reduce infection but this is labour intensive and costly. Furthermore, no effective biocontrol products have been developed and climate change could also be hampering traditional control methods.
Once trees are infected, the pathogen can spread within and between trees rapidly. Asexual spores (conidia) are produced on young and old cankers, and spread through rain splash, whilst sexual spores (ascospores) are produced on old cankers (Figure 2) some three to six months after infection. These ascospores are dispersed in the wind, enabling long-distance spread. In climates like the UK, 30 minutes of rainfall can produce between 1,000 and 10,000 spores per mm of canker lesion. Given that less than ten spores are required for infection, it is little wonder that the problem is so severe in our industry.

Figure 2: Magnified image of perithecia on an old canker lesion, which release ascospores
The spores infect trees at a range of wound sites including pruning wounds, picking wounds, growth cracks, lenticels, petal scars and leaf scars. With spores being produced all year round and points of entry available continuously, spread can be rapid. In the UK climate, if trees are not managed for canker, a single canker lesion can result in 100% of trees in an orchard becoming infected within six to seven years. Growers have historically




































































relied upon the use of fungicides such as captan, dithianon, dodine and tebuconazole applied at petal fall and leaf fall, but increasing restrictions and pending loss of many of these is increasing the pressure to find alternative control methods. Copper products were also very effective but are no longer authorised for use. However, it is worth noting that no fungicide sprays can kill cankers or stop them from sporulating. Leaf scar protection is possible using captan/tebuconazole programmes at high rates and high water volumes (800-1,000 l/ ha), but only if timed correctly (20, 50, 80% leaf fall) and if inoculum levels are low. Picking and pruning wounds are impossible to target and protect.
Many years of research in the UK, New Zealand and elsewhere have identified several cultural management practices that can help to reduce spread of Neonectria
ditissima. Removing cankers by pruning them out of the tree to reduce inoculum load is the best mitigation at the moment. It is especially important to remove old cankers that produce air borne ascospores and cankers of any age located high in the tree canopy where they can spread infection to every part of the tree below the canker every time it rains. There are four times of the year when this should be done. In order of importance:
1. Pre-picking/harvest – helping to remove inoculum which might infect picking wounds and leaf scars during leaf fall.
2. Post-harvest/before leaf fall – helping to remove inoculum that may infect leaf scars, pruning wounds and winter cracks. This pruning can be used in combination with leaf fall sprays.
3. Mid-winter – it can be easier to identify hot spots at this time of year.
4. Spring/early summer – autumn infections start to appear at bud burst/ flowering, presenting symptoms of shoots with dieback/dry leaves and flowers. These should be removed as soon as possible.
During these pruning periods, it is important to apply pruning paint to all pruning cuts to kill spores. Infected wood should be removed from the orchard and burnt or commercially composted off site. Secateurs and pruning tools should be sterilised routinely. It is also essential that nursery trees be monitored regularly in the early years of the tree life to remove peripheral cankers and replace trees that display mainstem cankers.
The cultural techniques to reduce inoculum load summarised above result in best reduction in disease spread when used in combination with products and control agents that are applied to protect leaf and other entry points. With conventional fungicide products in decline, a number of projects have been funded by AHDB, Growing Kent & Medway and The East Malling Trust to identify suitable alternatives including novel fungicides, biostimulants, defence elicitors, biocontrol agents, basic substances and combinations of these. They have been compared to a water control and standard grower treatment (captan/ tebuconazole/captan at 20%, 50% and 80% leaf fall).
Neither biostiumulants or defence elicitors were effective. A Trichoderma based biocontrol product and an azole based fungicide offered some decrease in canker incidence on infected trees, but only at lower inoculum levels on naturally infected wounds. Hydrated lime (e.g. building grade Hydrated lime Blue Circle) at a rate
of 50kg/ha in 300 litres of water, reduced canker incidence by more than 50% on small Gala/M9 trees in the first year after planting. The optimum dose and timing of application is currently being optimised, but larger spray volume (500-1000l/ha) is generally recommended by the work done in the Netherlands and New Zealand where hydrated lime is being used.
In recent years, AHDB, BBSRC and industry funding (Worldwide fruit, AM Fresh, Adrian Scripps Ltd) has enabled NIAB to research novel microbial amendments against canker such as endophytes. These are microorganisms (bacteria and fungi) that live within plant tissues and can have a pathogenic or symbiotic relationship within it. Fungal strains belonging to the genus Epicoccum and bacterial Sphingomonas strains have been isolated from canker tolerant apple varieties. Epicoccum nigrum demonstrated antagonism towards Neonectria ditissima in laboratory tests (Figure 3) and when scaled up to orchard trials, reduced leaf scar and pruning wound infections by 50%. A BBSRC funded followon project is currently investigating strains of Sphingomonas which are associated with both scion genetics and canker control, and also known to promote plant growth. NIAB is seeking to understand if it persists from season to season or whether repeated application is necessary.
In a project funded by Growing Kent & Medway and The East Malling Trust, NIAB is working with Agrovista and Avalon Fresh to assess the use of commercial mycorrhiza and Trichoderma based products applied to newly planted Gala orchards in both drought and waterlogged prone soils to improve tree establishment and potentially reduce canker impact. Canker incidence, tree mortality and tree growth is being recorded every six months to compare treatments.
The team is also seeking to improve the resilience of older, established orchards. Mycorrhizal fungi (Figure 4) are believed to improve soil drainage, soil health and nutrient uptake, to enhance tree health, tree growth and the ability to withstand pathogen infection. Different methods for increasing mycorrhiza in the orchard have been tested. One of these is to establish specific wildflower species that are known to support the growth of naturally occurring and introduced mycorrhiza. To date, the use of both wildflowers and wildflowers with added arbuscular mycorrhizal fungi have effectively increased mycorrhiza in the tested orchards. Further results from this work will become available at the end of 2024.
Other studies being funded by BBSRC and British Apples and Pears Ltd are exploring the impact of soil pH, soil organic matter and nutrient levels and soil type, on the
development of canker symptoms. This work stems from previous BBSRC/AHDB/ apple industry funded work which found that canker symptom expression on seven scion varieties on M9 varied dramatically between three sites in Kent. The trees planted on three sites came from the same nursery field, had the same levels of inoculum, and were managed in the same way on all three sites, pointing to the soil parameters as one possible reason for differences in canker expression.
As part of this work, NIAB is seeking help from apple growers to provide recent soil nutrient analyses and access to undertake canker assessments in commercial orchards, to identify if there is any correlation with canker development and soil nutrition. Anyone who is able to help should contact Matevz Papp-Rupar at: Matevz.papp-rupar@niab.com. ■

Figure 4: Magnified image of in virto culture of mycorrhiza


By Caroline Ashdown, AGPO and Joe Harvey, Worldwide Fruit Ltd.
Weather during the 2023 growing season
It seems that the weather is becoming more extreme from season to season.
In 2022 there was a bumper crop with a long period of drought that impacted on size profile, then 2023 brought a considerably smaller crop and a much cooler and wetter growing season. The driest month across all regions was February, September was kind to the Kent growers but then October saw very high rainfall everywhere, resulting in plenty of mud in the orchards.
Table 1: Comparison of the last six growing seasons – 2017/18 data supplied by FAST LLP at Brogdale, 2019 data onwards taken from Manston station recordings on Met Office website
February was below average rainfall across all regions, however March made up for the shortfall. There were regional differences seen in April, June and September. October onwards was very wet for all regions. In 2022 the total rainfall for East Anglia was 446mm, yet in 2023 it was 720mm and in Ross-on-Wye it was 829mm for 2023 compared to 648mm in 2022.
2023 started cold for Cambridge and Rosson-Wye with each site recording ten air frosts, compared to Manston only having four. There were some spells of warmer weather, but nothing as high as what was recorded in 2022. June and September were the two warmest months for all regions, so rather than the traditional peak in July/ August, the maximum temperatures had two spikes. The maximum average temperature was 24oc in Cambridge in June. August was considerably cooler than the 2023 season, with Ross-on-Wye hitting 21.1°C compared to 25.4°C the previous year.
The 2023 season in Kent saw 200 hours less sunshine compared to the previous season and was exactly the same as 2019. Across the year Ross-on-Wye was considerably down compared to 2022 and had an accumulative total of 1,363 hours compared to 1,714 hours in 2022. There are no sunshine hours available for Cambridge weather station.
higher by the time of picking. In some cases brix levels were 1-2% lower than what we saw in 2022, although it is worth noting that was an exceptional season.
Pressures steadily declined over a matter of weeks. On 10 August fruit firmness was averaging 8.9kg, in line with what we typically would see at this time. By the first week of September, most blocks were averaging below 7kg.
Graph 3 – Average monthly minimum temperature oc for all growing regions. All data obtained via Met Office website.
The following maturity data has been supplied by Worldwide Fruit Ltd, taken from Fruition PO assessments across various sites in Kent, throughout the 2023 season.
Sunshine hours
The 2023 season was much later than what was seen the year prior, with pick dates for some varieties one to two weeks later than in 2022.
Some of the earliest blocks were picked in the first week of September and by the end of the second week of September, all growers had finished picking conference.
The 2023 season in Kent saw 200 hours less sunshine compared to the previous season and was exactly the same as 2019. Across the year Ross-on-Wye was considerably down compared to 2022 and had an accumalative total of 1,363 hours compared to 1,714 hours in 2022. There are no sunshine hours available for Cambridge weather station.
Cox starches were much slower to develop in 2023 than in 2022. On average, most blocks did not meet the required <75% starch, for picking to commence for Long Term Storage, until 15 September.
The following maturity data has been supplied by Worldwide Fruit Ltd, taken from Fruition PO assessments across various sites in Kent, throughout the 202 3 season.
Initially, brix levels for conference were much lower than what we saw in the season prior, averaging just over 11% at the start of August. That said, after some cooler night time temperatures, towards the end of the month, brix levels developed sufficiently where many blocks were around 12% or
Brix levels were also slow to develop, and for many blocks, hovering around 10.5% through August and into September. It was not until a period of warmer weather in September that we saw brix levels increase. By 12 September, on average, brix levels were averaging 11.4%. For many orchards, brix levels were around 1% lower than in
The 2023 season was much later than what was seen the year prior, with pick dates for some varieties 1-2 weeks later than in 2022.
Cox starches were much slower to develop in 2023 than in 2022. On average, most blocks did not meet the required <75% starch, for picking to commence for Long Term Storage, until the 15th of September.
The slow to develop starches and lower levels of brix meant that Cox picking occurred later than what is typical. Some of the earliest blocks were picked around 11 September for long term storage.
Brix levels were also slow to develop, and for many blocks, hovering around 10.5% through August and into September. It was not until a period of warmer weather in September that we saw brix levels increase. By the 12th of September, on average, brix levels were averaging 11.4%. For many orchards, brix levels were around 1% lower than in 2022, throughout the build up to harvest.
Despite the later pick dates, pressures for fruit on the tree remained relatively high with many blocks averaging around 9kg by the time they were picked for storage.
Brix levels in Gala were slow to develop in the 2023 season, similar to what we saw with other varieties. Brix levels were 1%1.5% lower, in the build up to harvest, than what we saw in 2022 and our long-term averages.
The slow to develop starches and lower levels of brix meant that Cox picking occurred later than what is typical. Some of the earliest blocks were picked around the 11th of September for long term storage.
Despite the later pick dates, pressures for fruit on the tree remained relatively high with many blocks averaging around 9kg by the time they were picked for storage.
Finally, levels of water core were seen in blocks across many sites. This was most likely caused by a very wet August affecting Calcium uptake, followed by a warm September that caused an increase in
Pressures for Gala look to be lower in 2023 compared to the previous season, however this could be possibly down to the heavy crop from 2022 meaning more smaller fruit that had an impact on pressures. That said, by the time of harvest, for most blocks’ pressures were averaging 8.5kg-9kg.
Finally, levels of water core were seen in blocks across many sites. This was most likely caused by a very wet August affecting Calcium uptake, followed by a warm September that caused an increase in soluble solids.
Starches were late to begin moving, and did not break until around 5 September for many blocks. After that starch levels steadily declined, reaching 85% around 18 September.
Colour in fruit was slow to develop, particularly for the apples hidden under the canopy. There was a diurnal temperature difference of more than 10 degrees, but the night-time temperatures would have been still relatively high, 15 degrees or higher. Once the night-time temperatures began to drop, colour moved on considerably for most varieties.
Starch decline was in line with what we typically see. However, brix was initially quite low which resulted in some later than usual pick dates as growers allowed time for fruit to develop suitable brix levels. By the time of harvest, brix levels were averaging around 11.5% for most blocks.
Pressures were relatively firm when we initially began evaluating fruit at the end of September. However, pressures did come down in the build up to harvest and by 16 October, averaged 9.2kg. ■






























MAP-MARKER Moat Farm, Whetsted Road, Five Oak Green, Tonbridge, Kent, TN12 6RR
�� 01892 852406 USER-LARGE Philip Thomas
✉ phil@adrianscripps.co.uk
MAP-MARKER Cooting Road, Aylesham Industrial Estate, Canterbury, Kent, CT3 3EP
�� 01304 842280 USER-LARGE Jack Ayling
LOCATION-ARROW www.agricareuk.com
✉ jack@agricareuk.com
MAP-MARKER Rutherford House, Nottingham Science and Technology Park, Nottingham, NG7 2PZ
�� 0115 939 0202 USER-LARGE Mark Davies
LOCATION-ARROW www.agrovista.co.uk/fruit
✉ enquires@agrovista.co.uk
MAP-MARKER Unit 30, Macklet Industrial Estate, Small Dole, BN5 9XR
�� 01273 082195 USER-LARGE Aneeta Gupta
LOCATION-ARROW www.andermattuk.com
✉ aneeta.gupta@andermattuk.com
MAP-MARKER 2 Stockport Exchange, Railway Road, Stockport, SK1 3GG
�� 01614 753000 USER-LARGE Natalie Wong ✉ natalie.a.wong@basf.com
LOCATION-ARROW www.agricentre.basf.co.uk
MAP-MARKER Gribble Bridge Lane, Biddenden, Kent, TN7 8DF
�� 01580 291726
LOCATION-ARROW www.biddendenvineyards.com
LOCATION-ARROW www.bifga.org.uk
✉ info@biddendevineyards.co.uk
MAP-MARKER Unit 1 Wyvern Way, Henwood Industrial Estate, Ashford, Kent, TN24 8DW
�� 01233 367167 USER-LARGE Clare Addison ✉ salessuk@biobestgroup.com
LOCATION-ARROW www.biobestgroup.com
MAP-MARKER Lion House, Bell Lane, Uckfield, East Sussex, TN22 1QL
�� 01825 598450
LOCATION-ARROW www.bluerenewables.co.uk
✉ info@bluerenewables.co.uk
MAP-MARKER Weihoek 11, 4416PX Kruiningen, Zeeland, The Neatherlands
�� +31 113 50 13 73
LOCATION-ARROW www.burgmachinery.com
✉ info@burgmachinery.com
MAP-MARKER Unit 1, Hayle Farm, Horsmonden, Kent, TN12 8DZ
�� 07980 86 9733 USER-LARGE Trevor Underdown
✉ trevor@controlledatmosphereservices.com
LOCATION-ARROW www.controlledatmosphereservices.com
MAP-MARKER Coveris, Cromwell Road, Wisbech, Cambridgeshire, PE11 3ZN
�� 01945 427400 USER-LARGE Jessica Weaver ✉ hello@coveris.com
LOCATION-ARROW www.coveris.com
MAP-MARKER Huntingdon Business Centre, Huntingdon, Cambridgeshire
�� 0345 548 3436 USER-LARGE Neil Banks ✉ info@euro-statics.com
LOCATION-ARROW www.euro-statics.com
MAP-MARKER Berrington Court, Tenbury Wells, Worcs, WR15 8TH
�� 01584 810214 USER-LARGE Stephanie James ✉ enquires@fpmatthews.co.uk
LOCATION-ARROW www.frankpatthews.com
MAP-MARKER The Food Exchange, New Covent Garden Market, SW8 5EL
�� 0207 501 0300 ✉ info@fruitnet.com
LOCATION-ARROW www.fruitnet.com/fpj
MAP-MARKER Pottenved 3
�� 00316 57585026 USER-LARGE Frank van Rijk ✉ frank@fseurope.eu
LOCATION-ARROW www.fseurope.eu
MAP-MARKER Unit 2, Eden Business Centre, South Stour Ave, Ashford, Kent, TN23 7RS
�� 01233 623739 USER-LARGE Graham Elgar ✉ graham@gjelgarconstruction.co.uk
LOCATION-ARROW www.gjelgarconstruction.co.uk
MAP-MARKER Weasenham Lane, Wisbech, Cambridgeshire, PE13 2RN
�� 01954 461177
✉ information@hlhltd.co.uk
LOCATION-ARROW www.hutchinsons.co.uk
MAP-MARKER Tonbridge Road, Hadlow, Kent, TN11 0AL
MAIN SPONSOR
�� 01732 850551 USER-LARGE Alan Harvey ✉ alanharvey@northkent.ac.uk
LOCATION-ARROW www.hadlow.ac.uk
MAP-MARKER Orchard Place Business Park, Seven Mile Lane, Borough Green, Kent TN15 8LW
�� 07483 035922 USER-LARGE Richard Smith ✉ richard.smith@haynesgrp.co.uk
LOCATION-ARROW www.haynes-agri.co.uk
MAP-MARKER Grootgenhouterstraat 81, 6191 NR, Beek, The Netherlands
�� +31 46 428 0364 USER-LARGE Jeroen de Beste ✉ info@hermensfruitsystems.eu
LOCATION-ARROW www.hermensfruitsystems.eu
MAP-MARKER Unit 2 Owens Court Farm, Selling, Faversham, Kent
�� 01233 226284 USER-LARGE Phil Stanford ✉ sales@horsepoweragri.co.uk
LOCATION-ARROW www.horsepoweragri.co.uk
MAP-MARKER Park Farm, Park Farm Road, Kettlethorpe, Lincoln, LN1 2LD
�� 07714 103766 USER-LARGE Paul Wright ✉ Paul.Wright@hortifeeds.co.uk
LOCATION-ARROW www.hortifeeds.co.uk
MAP-MARKER Chittenden Orchards, Staplehurst, Kent, TN12 0EX
�� 01580 891756 USER-LARGE Peter Breach ✉ office@jrbreach.com
LOCATION-ARROW www.jrbreach.com
MAP-MARKER Unit R17, Rye Wharf, Rye Harbour Road, Rye, East Sussex, TN31 7TE
�� 01424 720121 USER-LARGE Keiran Lockton ✉ renewables@jencoelectrical.co.uk
LOCATION-ARROW www.jencoelectrical.co.uk
MAP-MARKER Old Walnut Tree Farm, Chapel Lane, Blean, CT2 9HE
�� 01227 765069
LOCATION-ARROW www.kentfruitservices.com
MAP-MARKER Griffins Farm, Pleasure House Lane, Maidstone, Kent, ME17 3NW
�� 01622 843013 USER-LARGE Hollie Kamel ✉ info@kirklanduk.com
LOCATION-ARROW www.kirkland.com
MAP-MARKER 37 St Margaret’s Street, Canterbury, Kent, CT1 2TU
�� 01227 768231 USER-LARGE Simon Budden ✉ simon.budden@krestonreeves.com
LOCATION-ARROW www.krestonreeves.com
MAP-MARKER 4 route de Beaupuy, 31180 Castelmaurou, France
�� 07929 069084 USER-LARGE Bryan Limerick ✉ blimerick@lallemand.com LOCATION-ARROW www.lallemandplantcare.com

MAP-MARKER 77 Commercial Road, Paddock Wood, Kent TN12 6DS
�� 01892 832325 USER-LARGE Tom Ogden ✉ agric@lambertandfoster.co.uk
LOCATION-ARROW www.lambertandfoster.co.uk
MAP-MARKER Lodge Farm, Goat Hall Lane, Chelmsford, Essex, CM2 8PH
�� 07788 318988 USER-LARGE Stephen Tulley ✉ stephen@landseerltd.co.uk
LOCATION-ARROW www.landseerltd.co.uk
MAP-MARKER 18 Henwood Road, Henwood Ind Est, Ashford, TN24 8DH
�� 01233 619290 USER-LARGE Jay Broster ✉ ashford@listerwilder.co.uk
LOCATION-ARROW www.listerwidler.co.uk
MAP-MARKER Avon Works, Cranbrook, Kent, TN17 2PT
�� 01580 712200 USER-LARGE Claire Seymour
✉ sales@npseymour.co.uk
LOCATION-ARROW www.npseymour.co.uk
MAP-MARKER 18 Smith Square, Westminster, London, SW1P 3HZ
LOCATION-ARROW www.nfuonline.com
MAP-MARKER 93 Lawrence Weaver Road, Cambridge, CB3 0LE

�� 01223 342200 USER-LARGE Scott Raffle ✉ scott.raffle@niab.com
LOCATION-ARROW www.niab.com
MAP-MARKER Bardney Airfield, Tupholme, Lincolnshire
�� 01526 396000 USER-LARGE Neil Holmes ✉ neilh@omex.com
LOCATION-ARROW www.omex.com
M79
MAP-MARKER Mayfield House, Lower Railway Road, Ilkley, LS29 8FL
�� 07758 820540 USER-LARGE Laura Stevens
✉ laura.stevens@onepay.co.uk
LOCATION-ARROW www.onepay.co.uk

MAP-MARKER Rumwood Green Farm, Sutton Road, Langley, Kent, ME17 3ND
�� 01622 861989 USER-LARGE Dave Reynolds ✉ info@orchardcooling.co.uk
LOCATION-ARROW www.orchardcooling.co.uk
MAP-MARKER One City Place,Queens Road, Chester CH1 3BQ
✉ findoutabout@oxbury.com
LOCATION-ARROW www.oxbury.com
MAP-MARKER Unit 1 Wensor Farm, Main Road, Hop Pole, Spalding, Lincs PE11 3HL
�� 01775 630900 USER-LARGE Nick Cesare ✉ sales@robotpalletizing.co.uk
LOCATION-ARROW www.robotpalletizing.co.uk
MAP-MARKER Howletts Barn, Woolton Barn, Bekesbourne Lane, Canterbury, Kent CT4 5EJ
�� 01304 849205 USER-LARGE Christine Disbury ✉ chirstine@plantexuk.com
MAP-MARKER Columbusweg 16, 4462 HB Goes, The Netherlands
�� +31 113 622 533 USER-LARGE Monique Schuit ✉ info@ribbstyle.com
LOCATION-ARROW www.ribbstyle.com
MAP-MARKER 8 Brook Business Park, Brookhampton Lane, Kineton, Warwickshire, CV35 0JA
�� 01926 800789 USER-LARGE Tom Archer
LOCATION-ARROW www.rootwave.com
✉ tom.archer@rootwave.com

MAP-MARKER Unit 7 Waterview Business Park, Castle Road, Sittingbourne, Kent, ME10 3SQ
�� 01795 843195 USER-LARGE Malcolm Cook ✉ malc.cook@smartcig.co.uk
LOCATION-ARROW www.smartcig.co.uk
MAP-MARKER The Granary, Downs Court, Yalding, Kent ME18 6AL
�� 01303 233883 USER-LARGE Jamie McGrorty
✉ jamie@southeastfarmer.net
LOCATION-ARROW www.southeastfarmer.net
MAP-MARKER Office 6, Allen House, New Spitalfields Market, 23 Sherrin Road, London, E10 5SQ
�� 0208 556 1479
USER-LARGE Jan Hutchinson ✉ jan@newspitalfieldsmarket.co.uk
LOCATION-ARROW www.newspitalfieldsmarket.co.uk
MAP-MARKER Branden Distribution Centre, Staplehurst Road, Marden, Tonbridge, Kent, TN12 9BT
�� 01580 893714
USER-LARGE Darren Goldup
✉ info@staplehursttransits.co.uk
LOCATION-ARROW http://www.staplehursttransits.co.uk
MAP-MARKER Paddock Wood, Kent, TN12 6DQ

�� 01892 831702 USER-LARGE Suzanne Pizzey ✉ uksales@storagecontrol.com
LOCATION-ARROW www.storagecontrol.co.uk
MAP-MARKER 21 Church St, Maidstone, ME14 1EN
�� 01622 695656 USER-LARGE Chris Tanton ✉ chris@actpub.co.uk
LOCATION-ARROW www.hortnews.com
MAP-MARKER Kent Showground, Detling, Maidstone, Kent, TM14 3JF
�� 01622 633058 ®
MAP-MARKER The Barn, Preston Garden Centre, The Street, Preston, Kent CT3 1ED
�� 01227 721437 USER-LARGE John Rogers ✉ john@torran.biz
MAP-MARKER Shop Street, Worlingworth, Woodbridge, Suffolk, IP1 7HU
�� 01728 628325 ✉ tpenquiries@tuckwells.co.uk
LOCATION-ARROW www.tuckwells.com
MAP-MARKER NIAB, New Road, East Malling, West Malling, ME19 6BJ
�� 07592 395803 USER-LARGE May Appleby ✉ may.appleby@niab.com
MAP-MARKER Unit 4 Hoads Farm, Moat Lane, Sedlescombe, TN33 0RY
�� 01424 813268 USER-LARGE John Hatch ✉ sales@ukcaltd.com
MAP-MARKER Kruislandsedijk 13, 4651 RH, Steenbergen, Holland �� 0031 167566924 USER-LARGE Han Verbeek ✉ info@verbeek.nu LOCATION-ARROW www.verbeek.nu
MAP-MARKER Pocklington Industrial Estate, Pocklington, York, YO42 1DN
�� 07768 598122 USER-LARGE Tracy Beilby ✉ tracy.beilby@yara.com LOCATION-ARROW www.yara.co.uk

Thanks to the following companies for their kind banner sponsorship

Knowledge




Specialists in controlled atmosphere stores
Rapid chilling systems for soft fruit and fresh produce
Secondary cooling systems with energy
efficient defrosting using air source heat pump technology
Retrofitting of existing high cost electrical defrost heaters with air source heat pumps
Electrical engineers and contracting
Refrigeration and Electrical service, maintenance, and breakdown cover




Testing and certification to NICEIC
Mains power solutions for distribution and installations
Temperature controlled wine storage solutions using DX or Secondary refrigeration with heating options
Qualified to install EV chargers
Refrigeration gas leak detection systems
F-gas compliance and record keeping
Refrigeration system controls with remote monitoring
M17 Adrian Scripps Ltd

M18 Agricare
M59 Agrovista UK Ltd
M69 Andermatt UK
M36 BASF plc
M40 Biddenden Vineyards
M34 Biobest UK Ltd
M71 Blue Renewables
M10a Burg Machinery B. V.
M78 CA Services Ltd
M62 Coveris
M31 Euro-Statics Ltd
M56 Frank P Matthews Ltd
M37 Fresh Produce Journal
M8 FS Europe BV
M53 G J Elgar
M20 H L Hutchinsons
M45 Hadlow College
M73 Haynes Agricultural Ltd
M63 Hermans Fruit Systems
M5 Horsepower UK Ltd
M47 Hortifeeds
M72 J R Breach / BIFGA
M11 JenCo Renewables
M10 Kent Fruit Services
M19 Kirkland UK
M66 Kreston Reeves
M39 Lallemand Plant Care
M52 Lambert & Foster
M77 Landseer Ltd

M3 Lister Wilder Ltd
M16 MFSS Education Team
M49 N P Seymour
M57 NFU
M42 NIAB/Growing Kent & Medway
M55 OMEX Horticulture
M79 OnePay
M70 Orchard Cooling Ltd
M35 Oxbury Bank Plc
M4 Pace Mechanical Handling Ltd
M60 Plantex UK
M46 Ribbstyle Selected Products B.V.
M13 RootWave (Ubiqutek Ltd)
M64 Smart CI Group Ltd
Floorplan is correct at the time of printing but is subject to change
M76 South East Farmer Magazine
M54 Spitalfields Market Tenants Association Staplehurst Transits
M75 Storage Control Systems Ltd
M33 The Fruit Grower
M41 The Kent County Agricultural Society
M44 Torran Construction Ltd
M12 Tuckwells
M43 UK Food Systems Centre for Doctoral Training
M51 UKCA Ltd
M7 Verbeek Boomkwekerijen B.V.
M74 Yara UK Ltd


























